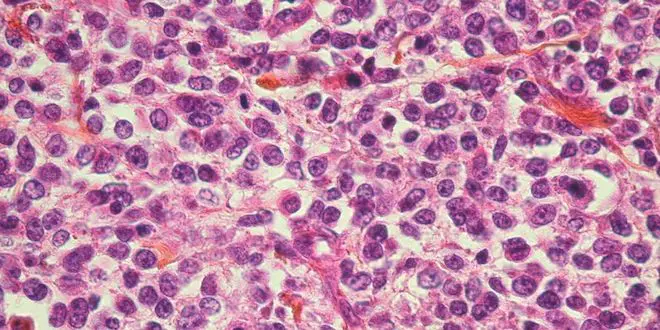

Un nouvel outil pour dépister des cellules cancéreuses
Un mini dispositif, muni d'un filtre spécial permettant d'isoler les cellules tumorales circulantes dans le sang, a été élaboré par le Pr Yvon Cayre, hématologue à l'université Pierre et Marie Curie de Paris. Une innovation qui pourrait bien révolutionner le dépistage de certains cancers et peut-être, par la suite, permettre d'éviter des biopsies invasives habituellement nécessaires pour confirmer un cancer.
Par La rédaction d'Allo Docteurs
Rédigé le
Le diagnostic d'un cancer est normalement effectué par une biopsie qui permet une analyse et la caractérisation des cellules cancéreuses au sein d'un tissu. Cet examen invasif - normalement incontournable pour confirmer la présence d'un cancer - n'est pas dénué de risques. Le Pr Yvon Cayre, ancien directeur d'Unité de recherche à l'INSERM, a inventé un nouvel outil pour isoler (par sélection) les cellules tumorales circulantes sanguines en fonction de leur taille. L'un des objectifs du Pr Cayre est que cet outil innovant permette un jour d'échapper à de nombreuses biopsies.
Un filtre capable de retenir les cellules tumorales
"Le dispositif que j'ai conçu est composé de plusieurs compartiments : un réservoir dans lequel on verse le sang (obtenu initialement d'une prise de sang standard), un filtre microporeux spécifique et une mèche permettant le passage du sang à travers le filtre. Une fois le sang du patient versé dans le dispositif de filtration, le filtre est capable de retenir les cellules tumorales circulantes du fait de leurs tailles, plus importantes que celles des cellules du sang. Même si quelques autres "grosses cellules" comme les monocytes peuvent parasiter parfois le filtre, elles ne sont pas confondues avec les cellules tumorales. La filtration achevée, le filtre peut alors être extrait du dispositif de filtration", explique le Pr Cayre.
Les caractéristiques physico-chimiques très particulières du filtre sont uniques, celui-ci a été développé dans le laboratoire de chimie du Pr Yong Chen à l'Ecole Normale Supérieure comme un produit de haute technologie. Après extraction, le filtre peut en effet être analysé au microscope, un peu comme une lame de microscope. Il est plat, transparent et résistant aux produits habituellement utilisés pour le marquage des cellules. Différentes analyses des cellules tumorales isolées peuvent alors être effectuées directement sur le filtre : le comptage après coloration, l'analyse morpho-cytologique et le marquage des cellules pour compléter leur caractérisation et détecter par exemple les anomalies génétiques.
"Pour le moment, le nouveau dispositif est dédié à la recherche et nous n'avons pas formulé de demande d'autorisation de mise sur le marché. Cependant, des travaux récents sur les cellules tumorales circulantes suggèrent fortement que leur détection pourrait permettre d'éviter dans de nombreux cas, des biopsies à des patients, et sur la base des travaux déjà réalisés, de nombreuses études sont en cours de développement sur différents types de cancer", poursuit le Pr Cayre.
Un outil de détection primaire
Les indications potentielles de l'utilisation de cet outil seront principalement des signes non spécifiques évocateurs de cancers ou encore des signes biologiques tels qu'un syndrome inflammatoire biologique sans cause évidente. "Il est important de rappeler que le nouveau dispositif de filtration n’a pas été conçu comme un substitut à la biopsie, mais comme un outil de détection primaire. La caractérisation de cellules suspectes isolées sur le filtre affirmant leur nature tumorale permettrait alors d'entreprendre un panel d'examens nécessaires tels que ceux habituellement pratiqués après biopsie", précise l'hématologue.
"50% des patients pourraient éviter la biopsie"
Le Pr Sabourin, gastro-entérologue au CHU de Rouen a évalué, dans une étude, l'intérêt de la recherche des cellules tumorales circulantes chez des patients atteints de cancers du pancréas en comparant leur détection à ceux obtenus après une biopsie à l'aiguille fine. Pour le Pr Sabourin, "environ 50% des patients pourraient éviter la biopsie". En d'autres termes et de façon saisissante, on pourrait dans certains cancers, ne pas avoir recours à la biopsie, mais seulement à l'analyse microscopique des cellules tumorales après une prise de sang standard.
Pour l'instant, cette conclusion est limitée à la recherche sur le cancer du pancréas. Mais dans un certain nombre cas non négligeable, la biopsie pourrait donc être remplacée par la recherche des cellules tumorales circulantes sanguines et leurs analyses au microscope. Bien évidemment, dans le cas où on ne retrouverait pas de cellule tumorale, il faudra avoir recours à la biopsie.
Un coût bien inférieur à une biospie
"Début 2014, nous allons collaborer avec le pôle européen de cancérologie Gustave-Roussy de Villejuif (Val de Marne), pour tester cet outil sur un nombre limité de patients sélectionnés et consentants. Ces patients bénéficieront bien sûr d'explorations habituelles avec biopsie. Un prélèvement de sang sera aussi filtré permettant entre autre d'analyser l'efficacité du dispositif de filtration dans le dépistage de certains cancers et le comparer à une biopsie. Il faut noter que le dispositif de filtration n'a à aucun moment de contact avec le patient. Le patient n'est exposé qu'à une prise de sang standard, la filtration du sang se faisant après réception du prélèvement, dans un laboratoire du site", conclut le Pr Cayre.
Dans la perspective d'une autorisation d'utilisation médicale ultérieure, ce dispositif de filtration pourrait permettre en plus de son caractère non-invasif pour le patient et son intérêt de dépistage, de réaliser d'une part des économies de santé non négligeables - permettant un coût bien inférieur à une biopsie - et d'autre part un dépistage précoce des rechutes lors des traitements "ciblés".
En savoir plus sur les cellules cancéreuses










